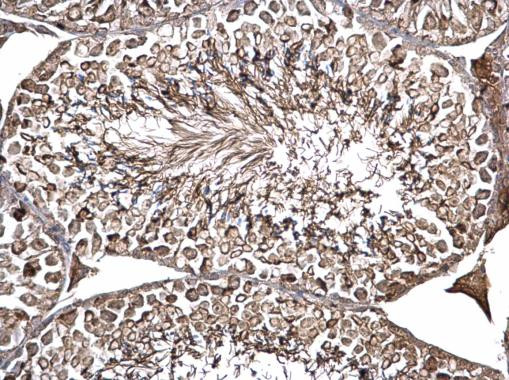
ODF2 Antibody in Immunohistochemistry (Paraffin) (IHC (P))

Search
Invitrogen
ODF2 Polyclonal Antibody
{{$productOrderCtrl.translations['antibody.pdp.commerceCard.promotion.promotions']}}
{{$productOrderCtrl.translations['antibody.pdp.commerceCard.promotion.viewpromo']}}
{{$productOrderCtrl.translations['antibody.pdp.commerceCard.promotion.promocode']}}: {{promo.promoCode}} {{promo.promoTitle}} {{promo.promoDescription}}. {{$productOrderCtrl.translations['antibody.pdp.commerceCard.promotion.learnmore']}}
图: 1 / 1
ODF2 Antibody (PA5-78407) in IHC (P)

产品信息
PA5-78407
种属反应
宿主/亚型
分类
类型
抗原
偶联物
形式
浓度
规格
纯化类型
保存液
内含物
保存条件
运输条件
RRID
产品详细信息
Predicted Reactivity: Human (100%), Rat (99%), Pig (97%), Rabbit (97%), Bovine (96%)
Store product as a concentrated solution. Centrifuge briefly prior to opening the vial.
靶标信息
Seems to be a major component of sperm tail outer dense fibers (ODF). ODFs are filamentous structures located on the outside of the axoneme in the midpiece and principal piece of the mammalian sperm tail and may help to maintain the passive elastic structures and elastic recoil of the sperm tail. May have a modulating influence on sperm motility. Functions as a general scaffold protein that is specifically localized at the distal/subdistal appendages of mother centrioles. Component of the centrosome matrix required for the localization of PLK1 and NIN to the centrosomes. Required for the formation and/or maintenance of normal CETN1 assembly.
⚠WARNING: This product can expose you to chemicals including mercury, which is known to the State of California to cause birth defects or other reproductive harm. For more information go to www.P65Warnings.ca.gov.
仅用于科研。不用于诊断过程。未经明确授权不得转售。
篇参考文献 (0)
生物信息学
蛋白别名: 84 kDa outer dense fiber protein; cancer/testis antigen 134; Cenexin; cenexin 1; hCenexin; Odf2/2; Outer dense fiber of sperm tails protein 2; outer dense fiber of sperm tails, 84-kD; Outer dense fiber protein 2; RP11-187B3.1; sperm tail structural protein; testis tissue sperm-binding protein Li 51e; unnamed protein product
基因别名: AI848335; CT134; MMTEST29; ODF2; ODF2/1; ODF2/2; ODF84
UniProt ID: (Human) Q5BJF6, (Mouse) A3KGV1
Entrez Gene ID: (Human) 4957, (Mouse) 18286